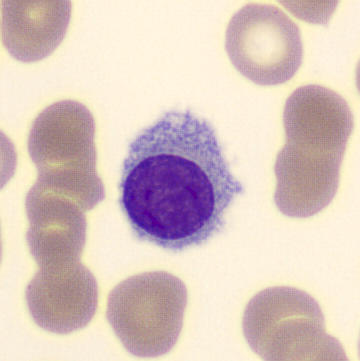
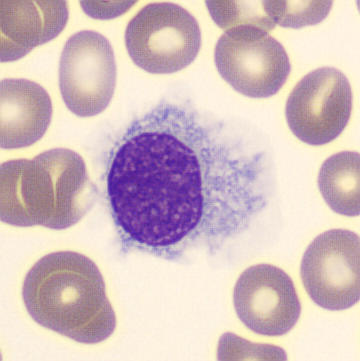
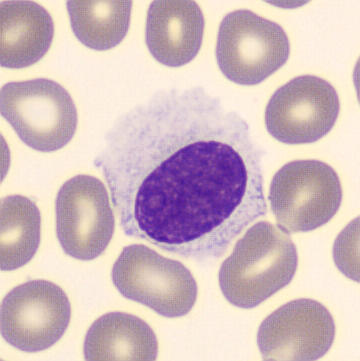

WDF - Hairy Cell Leukemia
SFL
SSC
Lymphocytes
Monocytes
Neutrophils
Eosinophils
Basophils
At first glance, this scatter shows a relatively normal distribution of leukocytes. However, upon closer inspection, it is noticeable that the monocyte population shows a lower than usual SFL signal . In addition, the angle relative to the x-axis for both the lymphocyte and monocyte populations is similar , whereas the monocyte population is normally positioned more steeply.
This scatter is appropriate for a hairy cell leukemia. The population counted as monocytes by the analyzer is actually hairy cells. Microscopically, complete monocytopenia is almost always observed.
Possible morphology